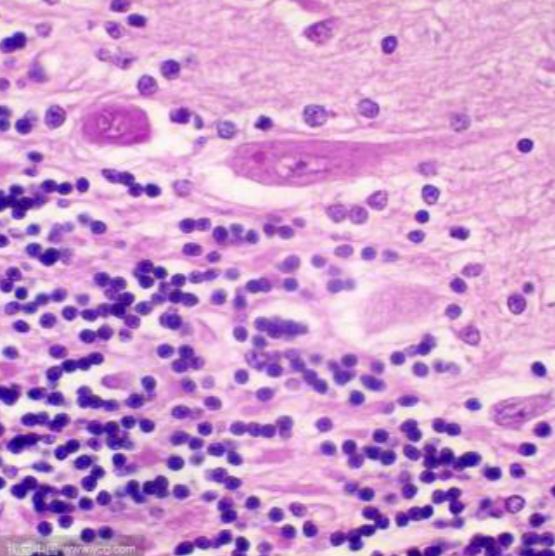
产品封面图

万千商家帮你免费找货
0 人在求购买到急需产品
- 详细信息
- 文献和实验
- 技术资料
- 提供商:
上海达为科生物科技有限公司
- 服务名称:
尼氏染色
一、技术原理与生物学意义
-
尼氏体的本质
尼氏体由粗面内质网和游离核糖体组成,富含RNA和酸性蛋白,是神经元合成功能蛋白的核心结构。其形态、分布和数量直接反映神经元功能状态:- 正常神经元:尼氏体呈块状或颗粒状,核周分布密集(如脊髓前角运动神经元)
- 受损神经元:尼氏体崩解、溶解或消失(染色质溶解现象),提示蛋白质合成受阻
- 再生神经元:尼氏体重新聚集,颗粒变细且均匀分布
-
染色机制
碱性染料(如焦油紫、亚甲蓝、甲苯胺蓝)通过静电作用与尼氏体内的RNA结合,形成稳定复合物。染色结果呈蓝紫色至深蓝色,细胞核浅染,背景透明。不同染料特性:染料类型 染色强度 适用场景 文献依据 焦油紫 高对比度 石蜡切片(神经元密度分析) 甲苯胺蓝 快速渗透 冰冻切片(术中快速诊断) 亚甲蓝 低背景干扰 活细胞动态观察 -
病理学意义
- 退行性疾病:阿尔茨海默病中皮层神经元尼氏体减少,与Tau蛋白磷酸化相关
- 缺血性损伤:脑缺血30分钟后海马CA1区尼氏体溶解,提示不可逆损伤
- 轴突反应:周围神经损伤后,背根神经节神经元尼氏体重新分布(中央染色质溶解)
二、实验流程与关键技术参数
(一)标准化操作流程
-
样本制备
样本类型 固定剂选择 处理要点 石蜡切片 中性福尔马林(4%, 24h) 脱蜡梯度:二甲苯→乙醇→水 冰冻切片 多聚jia醛(4%, 10min) 避免冻融循环,防脱片(明胶包被载玻片) 培养神经元 甲醇(-20℃, 10min) 轻柔冲洗,避免细胞脱落 -
染色步骤(以焦油紫法为例)
脱蜡至水
焦油紫染色10min蒸馏水漂洗酸性乙醇分化5s梯度乙醇脱水二甲苯透明中性树胶封片- 分化控制:分化液(0.1%盐酸乙醇)作用时间需显微镜下动态监测,至背景透明、尼氏体清晰
- 脱水梯度:95%乙醇→无水乙醇(各2min),避免残留水分影响封片
-
关键参数优化
- 切片厚度:石蜡切片5-10μm(常规分析),25μm(神经元密度统计)
- 染色温度:37-50℃预热染液可增强厚切片(30μm)渗透性
- 避光储存:染色后样本需避光保存,防荧光淬灭(荧光染料)
(二)质量控制体系
-
对照设置
- 阳性对照:DNase I预处理样本诱导DNA断裂,验证染色特异性
- 阴性对照:省略染色步骤或使用RNA酶消化,确认背景信号来源
-
结果判读标准
评分指标 0分(正常) 3分(重度损伤) 尼氏体完整性 颗粒均匀,边界清晰 完全溶解,仅核残留 细胞核形态 圆形,染色质均匀 固缩或碎裂 背景干扰 无非特异性染色 弥漫性着色影响观察

风险提示:丁香通仅作为第三方平台,为商家信息发布提供平台空间。用户咨询产品时请注意保护个人信息及财产安全,合理判断,谨慎选购商品,商家和用户对交易行为负责。对于医疗器械类产品,请先查证核实企业经营资质和医疗器械产品注册证情况。
文献和实验基础医学的重要学科之一。具体研究内容是细胞和组织的损伤、修复、代偿,局部血液循环障碍、炎症及肿瘤等的发生发展的一般规律,同时还进一步研究各种不同疾病的病因、病变的状况及其发生发展的特殊规律。病理学借助尸体剖检、活体组织检查、组织和细胞培养及动物实验等手段,研究从病体或实验动物取得的材料,经不同的观察方法进行细致的检查分析。常用的观察方法为大体观察(用肉眼进行观察、检测)、组织学观察(将病变组织制成切片,经一定处理后在显微镜下观察)、细胞学观察(将各种方法采集的脱落细胞制成细胞
秦惠基 疾病是一个极其复杂的过程。在病原因子和机体反应功能的相互作用下,患病机体有关部分的形态结构、代谢和功能都会发生种种改变,这是研究和认识疾病的重要依据。病理学(pathology)的任务就是运用各种方法研究疾病的原因(病因学,ethiology)、在病因作用下疾病发生发展的过程(发病学,Pathogenesis)以及机体在疾病过程中的功能、代谢
佚名 疾病是一个极其复杂的过程。在病原因子和机体反应功能的相互作用下,患病机体有关部分的形态结构、代谢和功能都会发生种种改变,这是研究和认识疾病的重要依据。病理学(patho1ogy)的任务就是运用各种方法研究疾病的原因(病因学,ethiology)、在病因作用下疾病发生发展的过程(发病学,pathogenesis)以及机体在疾病过程中的功能、代谢和形态结构的改变(病变
技术资料暂无技术资料 索取技术资料